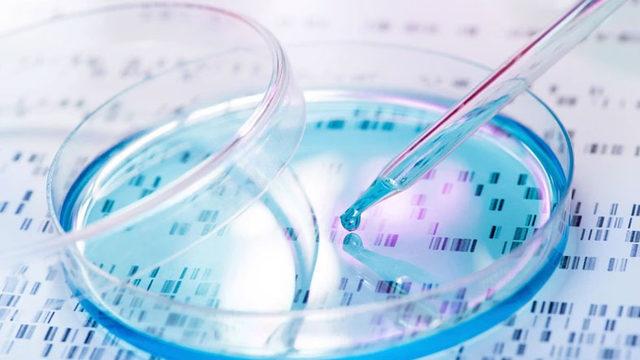
Bilim İnsanları, Gen Düzenleme Teknolojisi Kullanarak Yeni Bir Kanser Tedavisi Geliştirdi

Tüm canlılar doğarlar, yaşarlar ve ölürler. Bu, doğanın en önemli kanunlarından biridir. İnsanlarda da aynı şekilde ilerleyen bu süreç, çok uzun bir süredir araştırılıyor. Araştırmacılar, yaptıkları araştırmanın sonucunu almaya başlamış görünüyor. Biyolojik yaşlanmada temel rol oynayan gizemli bir gen keşfeden araştırmacılar, bu geni yaşa bağlı hastalıkların tedavi edilerek iyileştirilmesinde kullanmayı amaçlıyor.
Wisconsin-Madison Üniversitesi'nde görevli araştırmacılar tarafından gerçekleştirilen bu keşif, biyolojik yaşlanmayı önemli ölçüde yavaşlatıp tersine çevirmemizi sağlıyor. Çalışma, mezenkimal kök hücre (MKH) gençleştirme kullanılarak hücre yaşlanmasını tersine çevirmeyi hedefliyor.

Hücre yaşlanması nasıl tersine çevrildi?
Wisconsin-Madison Üniversitesi Biyomedikal Mühendislik Bölümü fakülte üyesi ve baş araştırmacı Wan-Ju Li, "Hücresel yeniden programlama yoluyla MKH gençleştirmeye dair önceki bulgulara katılsak da bizim çalışmamız daha ileriye giderek, yeniden programlanmış MKH'lerin, yaşlanmanın hücresel belirtilerini iyileştirmek için moleküler düzeyde nasıl düzenlendiğine dair içgörü sağlıyor" ifadelerini kullandı.
"En önemlisi hücredeki yaşlanmayla ilgili faaliyetleri kontrol eden temel mekanizmalardan biri olan, sinyalizasyon yolağını belirleyebildik." diyen Li, "Bulgularımızın MKH yaşlanmasına ve bunun rejeneratif önemine yönelik anlayışın geliştirilmesini sağlayacağını düşünüyoruz" ifadelerini kullanarak yaşlılığa bağlı hastalıkları büyük ölçüde engellemek istediklerini belirtti.

Bu hafta bilim dergisi Stem Cells'de yayımlanan araştırma, "çok önemli bir başarı" ifadesiyle nitelendirildi. Araştırmacılar, yaptıkları çalışmalarda diz ve dirsek eklemlerinde bulunan insan sinovyal sıvısından MHK'leri analiz ettiler. Bu MHK'leri dönüştürmeden önce pluripotent kök hücreler (canlıyı oluşturan tüm hücre tiplerine dönüşebilen gelişen bir embriyonun erken safhalarında ortaya çıkan farklılaşmamış hücreler) olacak şekilde yeniden programladılar. Bunun sonucunda da gençleştirilmiş MKH'ler elde edildi.
Yayımlanan makalede, "Yaşlanmayla ilgili faaliyetlerin MKH'lerde, ebeveyn soyundakilere kıyasla büyük ölçüde azaldığını saptadık. Bu da hücre yaşlanmasının tersine döndüğüne işaret ediyor" ifadeleri kullanıldı. Özellikle kemik erimesi, kıkırdak dejenerasyonunun iyileştirilmesi için üretilecek tedavilerde bu buluşun kritik bir öneme sahip olduğunu söyleyen Dr. Li, Parkinson ve kalp hastalıklarının tedavisinde de bu tedaviden yararlanma konusunda umutlu olduklarını söyledi.